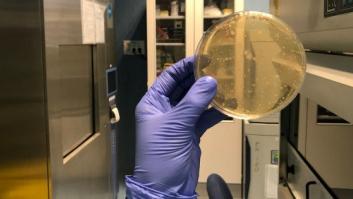
Del agar al hangar: cinco visitas que han enriquecido mi 2018

Javi Polinario
Javi Polinario

Un reportaje de Javi Polinario publicado en 'El HuffPost' gana el premio de la Fundación Grünenthal
Estos premios se conceden para sensibilizar a la sociedad sobre la problemática del dolor, que afecta a uno de cada cinco españoles.










